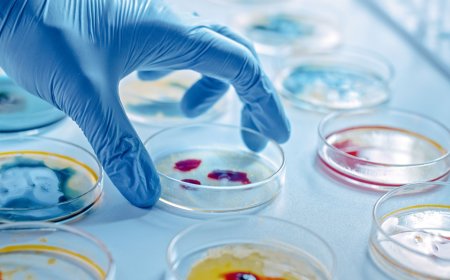
Antimicrobial Additives Market Size, Trends, and Strategic Outlook 2025-2032

Top 10 Omaha Spots for Seasonal Events
alex Nov 8, 2025 13
Top 10 Omaha Spots for Unique Souvenirs
alex Nov 8, 2025 9
Top 10 Omaha Spots for Outdoor Concerts
alex Nov 8, 2025 11
Top 10 Omaha Spots for Literary Events
alex Nov 8, 2025 7
Top 10 Omaha Spots for Night Markets
alex Nov 8, 2025 7
How to plan a solo trip to Omaha
alex Nov 8, 2025 5
How to find the best brunch in Omaha
alex Nov 8, 2025 2
How to book a yoga class in Omaha
alex Nov 8, 2025 5
How to plan a corporate retreat in Omaha
alex Nov 8, 2025 5
How to find the best pizza in Omaha
alex Nov 8, 2025 6
Midlands Choice Omaha Dental Support
alex Nov 8, 2025 7
Rotella's Italian Bakery Omaha Bread Quality ...
alex Nov 8, 2025 8
McCarthy Building Companies Omaha Safety Support
alex Nov 8, 2025 6
Lockton Omaha Employee Benefits Support
alex Nov 8, 2025 6
Supportworks Omaha Basement Waterproofing Sup...
alex Nov 8, 2025 8
Premium Spirits Market Insights: Growth, Shar...
research2512 Jul 11, 2025 12
ReddyBook In-Play Betting: How to Place Bets ...
alex Dec 20, 2025 8
680Unsecured.Loans – Fast, Flexible, Unsecure...
shivamisingh Jul 16, 2025 7
Best Personal Loan Options for ₹30,000 Monthl...
Abhay017 Jul 16, 2025 7
Why Cybersecurity Matters for Every Business ...
azsxdcf Jul 16, 2025 15
Lead Generation Services: Unlocking Business ...
ralphdashner Jul 16, 2025 14